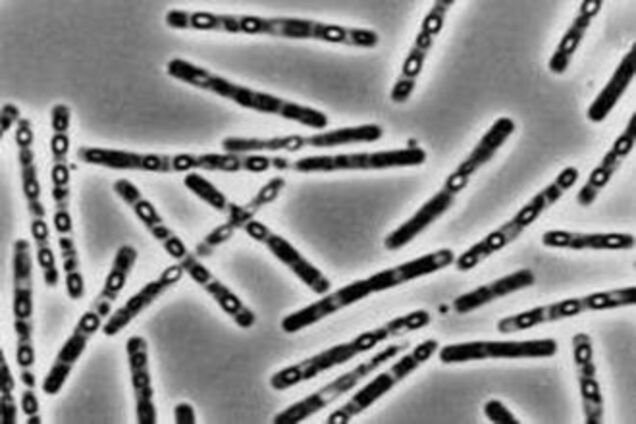

Сибирская Язва Фото Бактерии

💣 👉🏻👉🏻👉🏻 ИНФОРМАЦИЯ ДОСТУПНА ЗДЕСЬ! КЛИКАЙ 👈🏻👈🏻👈🏻
Лох Серебристый Фото И Описание Кустарника Цена
Избиение Прилучного В Калининграде Фото
Осенняя Рамка А4 Под Фото
Артисты Советского Кино Мужчины Фото И Фамилии
Змея В Мире Фото Большое Мире
Виды Ягодных Кустарников Фото И Названия
Прикольные Фото Спать
Буторин Владимир Федорович Семья Жена Дети Фото
Фото Блюда Узбекской Кухни
Тигр На Охоте Фото
Эротические Фото В Нижнем Белье
Почему Не Удаляются Фотографии С Телефона
Стиральная Машина Lg 6кг Фото
Диван Ами Мебель Лагуна Фото И Цены
Кроватки Для Новорожденных Своими Руками Фото
Жалюзи Орск Каталог Цены Фото 2022 Года
Картинки Красные В Горошек
Бульон Для Фаршированных Перцев Рецепт С Фото
Гостиницы Геленджика Фото
Скачать Фото Из Сети
Подпись Под Фото В Ворде
Ссылка На Яндекс Картинки
Фото На Грин Карт Москва
Смотреть Голые Фотографий Бесплатно
Французский Маникюр Гель Лаком Фото Пошагово
Картинка С Днем Рождения Имя Оля
Танки С Глазами Фото
Солнечные Ангелы Галины Чувиляевой Картинки
Скачать Картинку С Пожеланием Дорогой
Шкафы Дсп Фото
Олег Слепцов Фото
Карнавал Рио Девушки Фото
Перец Леся Фото
Картинки Чулки Секс Минет
Плов С Бараниной Рецепт С Фото
Поздравление С 50 Летием Мужчине Фото
Какие Карты Сбербанка Бывают Фото
Как Перенести Фото С Iphone На Imac
Фото С Днем Рождения Аня
Картинки Связанные С Информатикой И Компьютером
С Днем Рождения Мужа Подруги Прикольные Картинки
Погоня За Прошлым Актеры И Роли Фото
Смайлики Девочки Картинки
Поздравляем С Бракосочетанием Картинки Поздравления
Порно Домашнее Фото С Волосатыми Пиздами
Туфли Фото Самые Красивые
Картинка Лена Выглядит Еще
Картинки Мишек Для Срисовки Легкие
Крутые Фото Винкс
С Первым Днем Месячных Картинка
Модульные Диваны В Беларуси Фото И Цены
Фото Надежды Павловой Балерины
Картинки Человека Паука Квадратные
Сдобные Печенья Рецепт С Фото
Осенние Ногти Фото
Синержи Двери Межкомнатные Синерджи Каталог Цены Фото
Вставить Фото С Днем Рождения Сынок
Березовый Лист Осенью Фото
Засветы Кисок В Купальниках Фото Видео
Дом Под Ключ Красноярск Цены Фото Недорого
Паук Резьба Фото
Фото Покрытой Девушки Со Спины
Ю Кейли Пеларгония Фото И Описание Отзывы
Юлия Поломина В Реальной Жизни Фото
Худые Маленькие Фото
Скачать Бесплатно Аниме Картинки Грустные Парни
Помидоры Непас Отзывы Фото Описание
Вешенки Как Выглядят В Природе Фото
Картинка Где Много Друзей
Какие Бывают Черепахи Фото
Скачать Картинки Лев Бесплатно
Горы Алматы Фото Хорошее Качество
Фасады Дворцов Фото
Скачать Бесплатно Картинки Машины Бмв
Фотографии Детей Спб
Спецназ Гру Картинки На Заставку
Самому Лучшему Сыну На Свете Картинки
Показать Картинку Небо
Фото Ххх В Полный Рост
Джонатан Яблоки Фото
Современная Гостиная 2022 Фото
Мультяшная Пчела Картинки На Аву
Как Закрыть Бойлер В Туалете Красиво Фото
Растения Фото Детям
Гремиха Госпиталь Операции Фото
Киа Сид Универсал 2022 Года Фото
Гортензия Мэджикал Флейм Описание И Фото
Фильм Любовь В Словах И Картинках
Как Поменять Фотографию В Культуре
Персиковый Маникюр Фото
Дарья Грачева Фото
Диана Енакаева Родители Фото
Картинки Слово Смерти Скачать
Встроенные Малогабаритные Кухни Фото
Фото Поршня Ваз
Волчьи Ягоды Кустарник Фото И Описание
Лиз Кембридж Горячие Фото
Картинки Маленькие Девушки Скачать
Картинка Прозрачный Стакан
Шрамы На Спине Фото
Найти Название Цветка По Фото Яндекс
Нарисованные Картинки Дерево Бревна Тележки
Роза Грехам Томас Фото И Описание Отзывы
Сибирская Язва Фото Бактерии

_illustration.jpg" width="550" alt="Сибирская Язва Фото Бактерии" title="Сибирская Язва Фото Бактерии">





h_358" width="550" alt="Сибирская Язва Фото Бактерии" title="Сибирская Язва Фото Бактерии">al_c" width="550" alt="Сибирская Язва Фото Бактерии" title="Сибирская Язва Фото Бактерии">q_80" width="550" alt="Сибирская Язва Фото Бактерии" title="Сибирская Язва Фото Бактерии">usm_0.66_1.00_0.01/Image-empty-state.jpg

